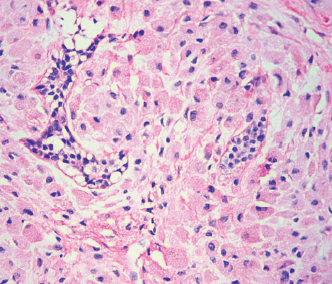

齒源性腫瘤 Odontogenic Tumor
- 上皮組織惡性病變: carcinoma
- 間葉組織惡性病變: sarcoma
- 上皮性來源(tumors of odontogenic epithelium)
- Ameloblastoma (2nd)
- Clear cell odontogenic carcinoma
- Adenomatoid odontogenic tumor (4th)
- Calcifying odontogenic tumor
- Squamous odontogenic tumor
- 混和性來源(mixed odontogenic tumors)來自上皮+外胚層間葉
- Ameloblastic fibroma
- Ameloblastic fibro-odontoma
- Ameloblastic fibrosarcoma
- Odontoma (1st)
- Primordial odontogenic tumor
- 外胚層間葉來源(tumors of odontogenic ectomesenchyme)
- Odontogenic fibroma
- Granular cell odontogenic tumor
- Odontogenic myxoma (3^rd)
- Cementoblastoma
上皮性來源
| 原因 | 位置 | 年齡 | 特徵 | |||
|---|---|---|---|---|---|---|
| Ameloblastoma | 多囊腫型 (coventional solid or multicystic intraosseous) |
|
下顎 (80-85%) | - |
|
|
follicular Pattern
 |
||||||
plexiform pattern
 |
||||||
basal cell pattern
 |
||||||
acanthomatous pattern |
||||||
granular cell pattern
 |
||||||
| 前牙 | desmoplastic pattern
 |
|||||
| 單一囊腫型(unicystic) | 下顎後 | ~23y |
 |
|||
luminal ameloblastoma  |
||||||
| intraluminal ameloblastoma 多為 plexiform type  |
||||||
mural ameloblastoma  |
||||||
| 骨外囊腫型(peripheral/ extraosseous) | 下顎後、軟組織限 | 52y | plexiform 或是 follicular pattern  |
|||
| 局部切除, 15-20% 復發 | ||||||
| Ameloblastic Carcinoma | - | 下顎後側 | 50-60y | 放射線 不規則,邊界不清楚。 |
||
| Calcifying epithelial odontogenic tumor (CEOT) | - | 下顎 | 30-50y |
 |
||
  |
||||||
| Adenomatoid odontogenic tumor (AOT) | - | 上顎、前牙、犬齒、頰側 | 10-19y | Tumor of two-third
|
||
| 無痛小病灶(φ<3cm),變大時骨膨脹 | ||||||
radiolucency 跨過 CEJ,可能有鈣化  |
||||||
 |
||||||
| Squamous odontogenic tumor | 錯位 | 上顎前,下顎後 | - |
 |
||
| Clear cell odontogenic carcinoma | biphasic | 一堆 Clear cell, 一堆 Glycogen | - | - |
 |
|
| monophasic | - | - | - |
 |
||
| ameloblastoma-like | - | - | - |
 |
||
混和性來源
| 原因 | 位置 | 年齡 | 特徵 | |||
|---|---|---|---|---|---|---|
| Ameloblastic fibroma | - | 下顎臼齒區 | 20y ↓ |
  |
||
| Ameloblastic fibrosarcoma | Ameloblastic fibroma 惡化 | 下顎(80%) | 27.5y (1.5:1) |
|
||
|
||||||
| Odontoma | compound | 最常見 | 上顎前牙 | 20y ↓ |
  |
|
| complex | 後牙 |
  |
||||
| Ameloblastic fibro-odontoma | Ameloblastic fibroma + Odontoma | 下顎後 | 10y |
 |
||
| Primordial Odontogenic Tumor 新 | - | 下顎後牙(3^rd 大臼齒, 乳臼齒) | 10y-20y |
 |
||
| – | ||||||
外胚層間葉來源
| 原因 | 位置 | 年齡 | 特徵 | |||
|---|---|---|---|---|---|---|
| Odontogenic fibroma | central type罕 (骨內) | - | 上顎為第一大臼齒以前、下顎為第一大臼齒以後 | 未萌發的牙齒(5%) |
 |
|
Simple, WHO  |
||||||
| peripheral type (軟組織) | - | 下顎牙齦 facial | 10-40y | 又稱 Odontogenic epithelial harmatoma, Peripheral fibroameloblastic dentinoma | ||
  |
||||||
| Granular Cell Odontogenic tumor | - | - | - |
|
||
| Odontogenic myxoma 齒源性黏液瘤 |
- | 顎骨限(下顎稍高) | 25-30y |
  |
||
| 間質淡粉紅色,看不太到 collagen fiber | ||||||
| Cementoblastoma | cementoblast 狂做 | 下顎(75%),後牙(90%),下顎第一大臼齒(50%) | <20y (50%) |
 |
||
  |
||||||
齒源性腫瘤、Cyst 整理
- 良性,但棘手,高復發
- OKC (局部侵犯,切不乾淨)
- GOC (局部侵犯)
- Ameloblastoma (局部侵犯)
- 惡性 → Ameloblastic fibrosarcoma (侵犯又快又痛)
- myxoma: 長得慢,但拿不乾淨
- 頰舌擴張
- BBC
- 多房 Ameloblastoma
- 非下顎好發
- EC: 乳前牙, 第一大臼齒
- COC: 前牙,上下一樣多
- AOT: 上顎前牙犬齒頰側
- Squamous odontogenic tumor: 上顎前,下顎後
- compound Odontoma: 上顎前牙
- Odontogenic fibroma: 上顎為第一大臼齒以前、下顎為第一大臼齒以後
| 男性較多 | 女性較多 |
|---|---|
| OOC odontogenic carcinoma NDC EC Stafne Defect Simple Bone Cyst 長骨型 |
Nasolabial Cyst Gardner syndrome Pilar cysts |
| 必定伴隨阻生牙 | 可能伴隨阻生牙 | 一定不伴隨阻生牙 |
|---|---|---|
|
|
|
| 牙根吸收 | 牙根不太吸收 |
|---|---|
|
|
|
|
|
| 正角化上皮 | 不完全角化上皮 | 非角化上皮 |
|---|---|---|
|
|
|
| 單房 Unilocular | 多房 Multilocular |
|---|---|
| OOC COC Simple Bone Cyst |
GOC Ameloblastoma |